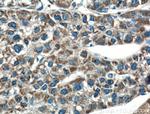
USP30 Antibody in Immunohistochemistry (Paraffin) (IHC (P))

Search
Proteintech
USP30 Polyclonal Antibody
{{$productOrderCtrl.translations['antibody.pdp.commerceCard.promotion.promotions']}}
{{$productOrderCtrl.translations['antibody.pdp.commerceCard.promotion.viewpromo']}}
{{$productOrderCtrl.translations['antibody.pdp.commerceCard.promotion.promocode']}}: {{promo.promoCode}} {{promo.promoTitle}} {{promo.promoDescription}}. {{$productOrderCtrl.translations['antibody.pdp.commerceCard.promotion.learnmore']}}
产品信息
15402-1-AP
种属反应
宿主/亚型
分类
类型
抗原
偶联物
形式
纯化类型
保存液
内含物
保存条件
运输条件
产品详细信息
Immunogen sequence: VITSSLEDER DRQPRVTHLF DVHSLEQQSE ITPKQITCRT RGSPHPTSNH WKSQHPFHGR LTSNMVCKHC EHQSPVRFDT FDSLSLSIPA ATWGHPLTLD HCLHHFISSE SVRDVVCDNC TKIEAKGTLN GEKVEHQRTT FVKQLKLGKL PQCLCIHLQR LSWSSHGTPL KRHEHVQFNE FLMMDIYKYH LLGHKPSQHN PKLNKNPGPT LELQDGPGAP TPVLNQPGAP KTQIFMNGAC SPSLLPTLSA PMPFPLPVVP DYSSSTYLFR LMAVVVHHGD MHSGHFVTYR RSPPSARNPL STSNQWLWVS DDTVRKASLQ EVLSSSAYLL FYERVLSRMQ HQSQECKSEE
靶标信息
USP30, a member of the ubiquitin-specific protease family, is a novel mitochondrial deubiquitinating (DUB) enzyme (Nakamura and Hirose, 2008).
仅用于科研。不用于诊断过程。未经明确授权不得转售。
篇参考文献 (0)
生物信息学
蛋白别名: Deubiquitinating enzyme 30; FLJ40511; MGC10702; Ub-specific protease 30; Ubiquitin carboxyl-terminal hydrolase 30; ubiquitin specific protease 30; Ubiquitin thioesterase 30; ubiquitin thiolesterase 30; ubiquitin-specific protease 30; Ubiquitin-specific-processing protease 30; unnamed protein product
基因别名: 6330590F17Rik; AI851327; D5Ertd483e; USP30
UniProt ID: (Human) Q70CQ3, (Rat) D3ZPG5, (Mouse) Q3UN04
Entrez Gene ID: (Human) 84749, (Rat) 304579, (Mouse) 100756